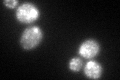
YDR189W

View description
Hydrophilic protein involved in vesicle trafficking between the ER and Golgi; SM (Sec1/Munc-18) family protein that binds the tSNARE Sed5p and stimulates its assembly into a trans-SNARE membrane-protein complex
Localization:
Intensity:
Fold change:
Significance:
-
C’ GFP library in SD

punctate53.59 -
N' NOP1pr-GFP in SD

cytosol,punctate123.525 -
N' TEF2pr-mCherry in SD

cytosol140.452 -
N' NATIVEpr-GFP in SD

punctate34.8233 -
N' TEF2pr-VC and Cyto-VN in SD

cytosol56.2253 -
C’ GFP library in SD+DTT
punctate63.161.17No -
C’ GFP library in SD+H2O2

punctate52.770.98No -
C’ GFP library in Starvation Media

punctate61.61.14No -
C’ GFP library on the background of Pup2-DaMP

punctate -
C’ GFP library on the background of CCT mutant

punctate39.9530.74538No
